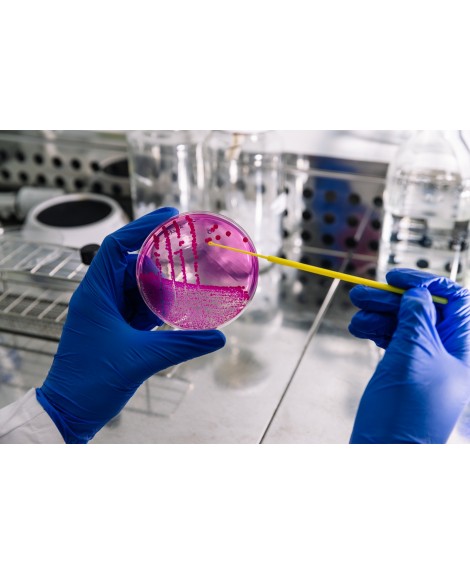
Cuando la alimentación influye en tu tratamiento: el caso del Sintrom
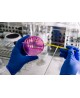
Cuando la alimentación influye en tu tratamiento: el caso del Sintrom

Cuando la alimentación influye en tu tratamiento: el caso del Sintrom
¿Puede lo que comemos modificar el efecto de un tratamiento médico? En el caso de las personas anticoaguladas, la alimentación influye directamente en la estabilidad del INR y en la eficacia del Sintrom.
En esta sesión abordaremos:
- Cómo interactúan determinados alimentos con el tratamiento anticoagulante.
- Qué es el INR y por qué puede alterarse.
- Ejemplos prácticos para la vida diaria.
- Reflexión más amplia sobre el papel real de la alimentación en la salud.
Participarán:
- Hematóloga especialista.
- Profesional del acompañamiento social.
Una conversación cercana y divulgativa para comprender mejor cómo tomar decisiones informadas en el día a día.
40 plazas